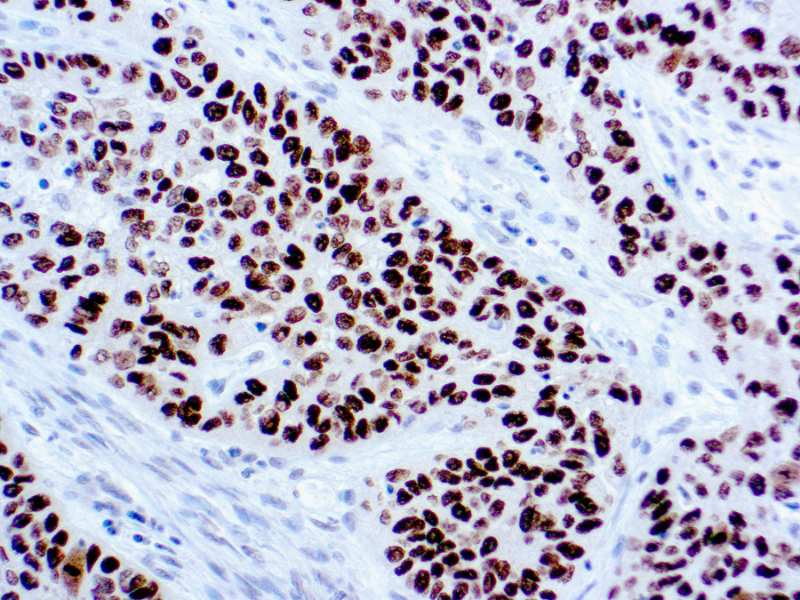

p40 is a relatively unknown antibody that recognizes ?Np63-a p63 isoform suggested to be highly specific for squamous/basal cells. In a recent study, p40 is equivalent to p63 in sensitivity for squamous cell carcinoma, but it is markedly superior to p63 in specificity1, which eliminates a potential pitfall of misinterpreting a p63-positive adenocarcinoma or unsuspected lymphoma as squamous cell carcinoma. These findings strongly support the routine use of p40 in place of p63 for the diagnosis of
0.5 ml
| Clone | Polyclonal Rabbit |
| Isotype | n.a |
| Application | IHC |
La documentation sera disponible sous peu. En attendant, vous pouvez nous contacter par email à l'adresse specialist@histoline.com